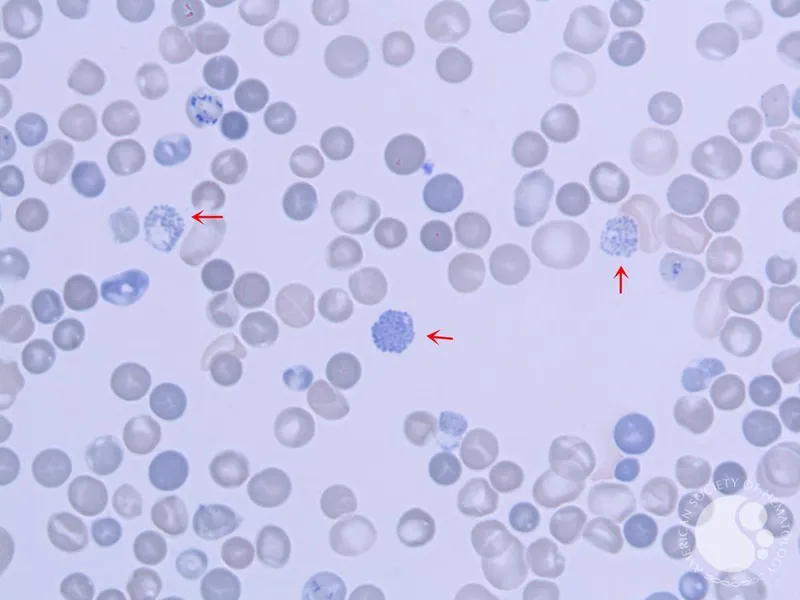
Peripheral smear of HbH disease with golf ball cells

Thalassemia Basics - Globin Chain Gang
- Quantitative defect in globin chain synthesis (α or β), leading to a microcytic, hypochromic anemia.
- The imbalance of chains causes ineffective erythropoiesis and hemolysis.
- Normal Adult Hemoglobins:
- HbA (Adult): $α_2β_2$ (~95-98%)
- HbA2 (Adult 2): $α_2δ_2$ (~2-3%)
- HbF (Fetal): $α_2γ_2$ (<2%)

⭐ Heterozygous thalassemia carriers show increased resistance to severe P. falciparum malaria.
Alpha-Thalassemia - Alpha's Missing Acts
- Pathophysiology: Caused by α-globin gene deletions on chromosome 16. Severity depends on the number of deleted genes (out of 4).
- cis deletion (prevalent in Asian populations) vs. trans deletion (prevalent in African populations).
- Clinical Spectrum:
- 1 deletion: Silent carrier, asymptomatic.
- 2 deletions: α-thalassemia trait with mild microcytic anemia.
- 3 deletions: HbH disease, where excess β-globin forms $β_4$ tetramers. Leads to severe hemolytic anemia & splenomegaly.
- 4 deletions: Hydrops fetalis (Hb Barts), where excess γ-globin forms $γ_4$ tetramers. It is lethal in utero.
⭐ In HbH disease, the precipitated $β_4$ tetramers (Heinz bodies) are visualized on supravital staining, giving RBCs a characteristic "golf ball" appearance.
Beta-Thalassemia - Beta's Bad Build
- Pathophysiology: Point mutations in the β-globin gene on chromosome 11 → ↓ or absent β-globin chain synthesis.
- Types:
- Minor (Trait): Heterozygous. Asymptomatic with mild microcytic anemia.
- Major (Cooley's Anemia): Homozygous. Severe, transfusion-dependent anemia.
- Clinical Features (Major):
- Ineffective erythropoiesis & extramedullary hematopoiesis → massive hepatosplenomegaly.
- Marrow expansion → "crew-cut" skull X-ray & "chipmunk" facies.
- Presents around 6 months as fetal hemoglobin (HbF) wanes.
- Diagnosis (Electrophoresis):
- ↓ HbA ($α₂β₂$)
- ↑ HbA₂ ($α₂δ₂$)
- ↑ HbF ($α₂γ₂$)

⭐ High-Yield: An elevated HbA₂ level (> 3.5%) is the key diagnostic finding for β-thalassemia minor (trait).
Diagnosis & Management - Spot & Support
- Management Strategy:
- Mild (carrier): Genetic counseling.
- Moderate/Severe (Major):
- Chronic Blood Transfusions: Maintain Hb >9-10 g/dL to support growth and suppress extramedullary hematopoiesis.
- Iron Chelation: Essential to prevent secondary hemochromatosis. Agents include Deferoxamine, Deferasirox.
- Splenectomy: Considered if hypersplenism increases transfusion requirements.
- Curative Option: Allogeneic hematopoietic stem cell transplantation.
⭐ High-Yield: In β-thalassemia minor, HbA2 levels are characteristically elevated (>3.5%) on electrophoresis, a key diagnostic differentiator.
High‑Yield Points - ⚡ Biggest Takeaways
- α-thalassemia is caused by gene deletions on chromosome 16; β-thalassemia results from point mutations on chromosome 11.
- Hallmark is microcytic anemia with a normal or ↑ RBC count and a very low MCV.
- Unlike iron deficiency, serum iron and ferritin levels are normal or elevated.
- Hb electrophoresis is key for diagnosis, showing ↑ HbA2/HbF in β-thalassemia.
- Severe forms (β-thal major, HbH disease) require lifelong blood transfusions and iron chelation therapy.
Unlock the full lesson and continue reading
Signup to continue reading this lesson and unlimited access questions, flashcards, AI notes, and more